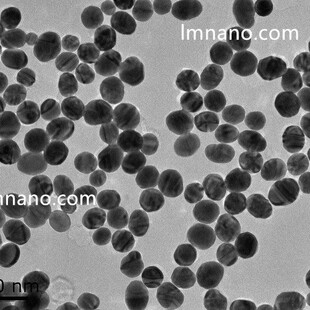
德科岛金 各种规格 亲和素金纳米颗粒

纳米金颗粒

金纳米颗粒Au/银纳米颗粒Ag/纳米金水溶液2nm~200nm/层析 胶体金


金纳米颗粒 纳米金胶体 水溶性金纳米颗粒 (3-100纳米可选)


高纯碳化锆粉 锆颗粒 金属碳化锆 锆粒 超细微米纳米碳化锆科研


金纳米颗粒 纳米金胶体 水溶性金纳米颗粒 (纳米选)


高纯碳化铪粉 氧化铪粉 氮化铪粉 金属铪颗粒 微米纳米科研氧化铪


高纯氧化镝粉末超细微米纳米三氧化二镝 稀土金属镝块镝颗粒科研


中科科优 金纳米颗粒子 葡聚糖纳米金颗粒 5nm-100nm多尺寸定制


200nm 水性球形金纳米颗粒 生物免疫检测、蛋白标记等


200nm 水性球形金纳米颗粒 生物免疫检测、蛋白标记等


德科岛金 不同尺寸 金纳米立方颗粒


德科岛金 不同尺寸 金纳米立方颗粒


德科岛金 各种规格 亲和素金纳米颗粒


德科岛金 各种规格 亲和素金纳米颗粒


德科岛金 各种规格 链霉亲和素修饰银纳米颗粒

德科岛金 各种规格 亲和素金纳米颗粒


德科岛金 各种规格 PEG化银纳米颗粒


德科岛金 各种规格 PEG化银纳米颗粒


德科岛金 各种规格 PEG化银纳米颗粒


各种粒径 PEG化球形金纳米颗粒


80nm 油溶性球形金纳米颗粒


80nm 油溶性球形金纳米颗粒


80nm 油溶性球形金纳米颗粒


金纳米颗粒 纳米金胶体 水溶性金纳米颗粒 (3-100纳米可选)


金纳米颗粒 纳米胶体金 免疫层析 生物试剂 高校科研 顺丰包邮


铬粉高纯铬粉末金属铬粉微米纳米超细铬粉纯铬颗粒铬粒块镀膜铬粉


金纳米颗粒 纳米金胶体 水溶性金纳米颗粒 (纳米选)


金佰牧黄金离子钙纳米颗粒钙虾蟹补钙小龙虾补钙螃蟹补钙颗粒钙


金纳米手性颗粒金纳米颗粒溶液科研实验专用厂家直供金胶体


立方碳化硼粉末B4C超硬耐磨碳化硼颗粒纳米微米高纯超细碳化硼粉


金纳米星颗粒科研实验室专用金胶体厂家直供


球形金纳米颗粒-水溶性金纳米颗粒-油溶性金纳米颗粒


超细纳米铂粉贵金属铂金纳米颗粒≤20nm高纯99.95%催化性能好零售


微球金纳米颗粒Au/银纳米颗粒Ag/胶体金水溶液


中科科优 金纳米颗粒 柠檬酸纳米金粒子球 胶体金 多尺寸支持定制


中科科优 金纳米颗粒 纳米黄金粒子 化妆品科研专用 官方直营包邮


中科科优 金纳米颗粒 生物素金纳米粒子 多尺寸定制 官方直营包邮


GB/T 34168-2017金、银纳米颗粒材料生物效应的透射电子显微镜检测方法


银纳米颗粒银纳米溶液纳米金胶体 浓度粒度


中科科优 金纳米颗粒 PEI修饰修饰金纳米粒子多规格可选 胶体金


中科科优 金纳米颗粒 羊多抗金纳米粒子 多尺寸可选 纳米金胶体




